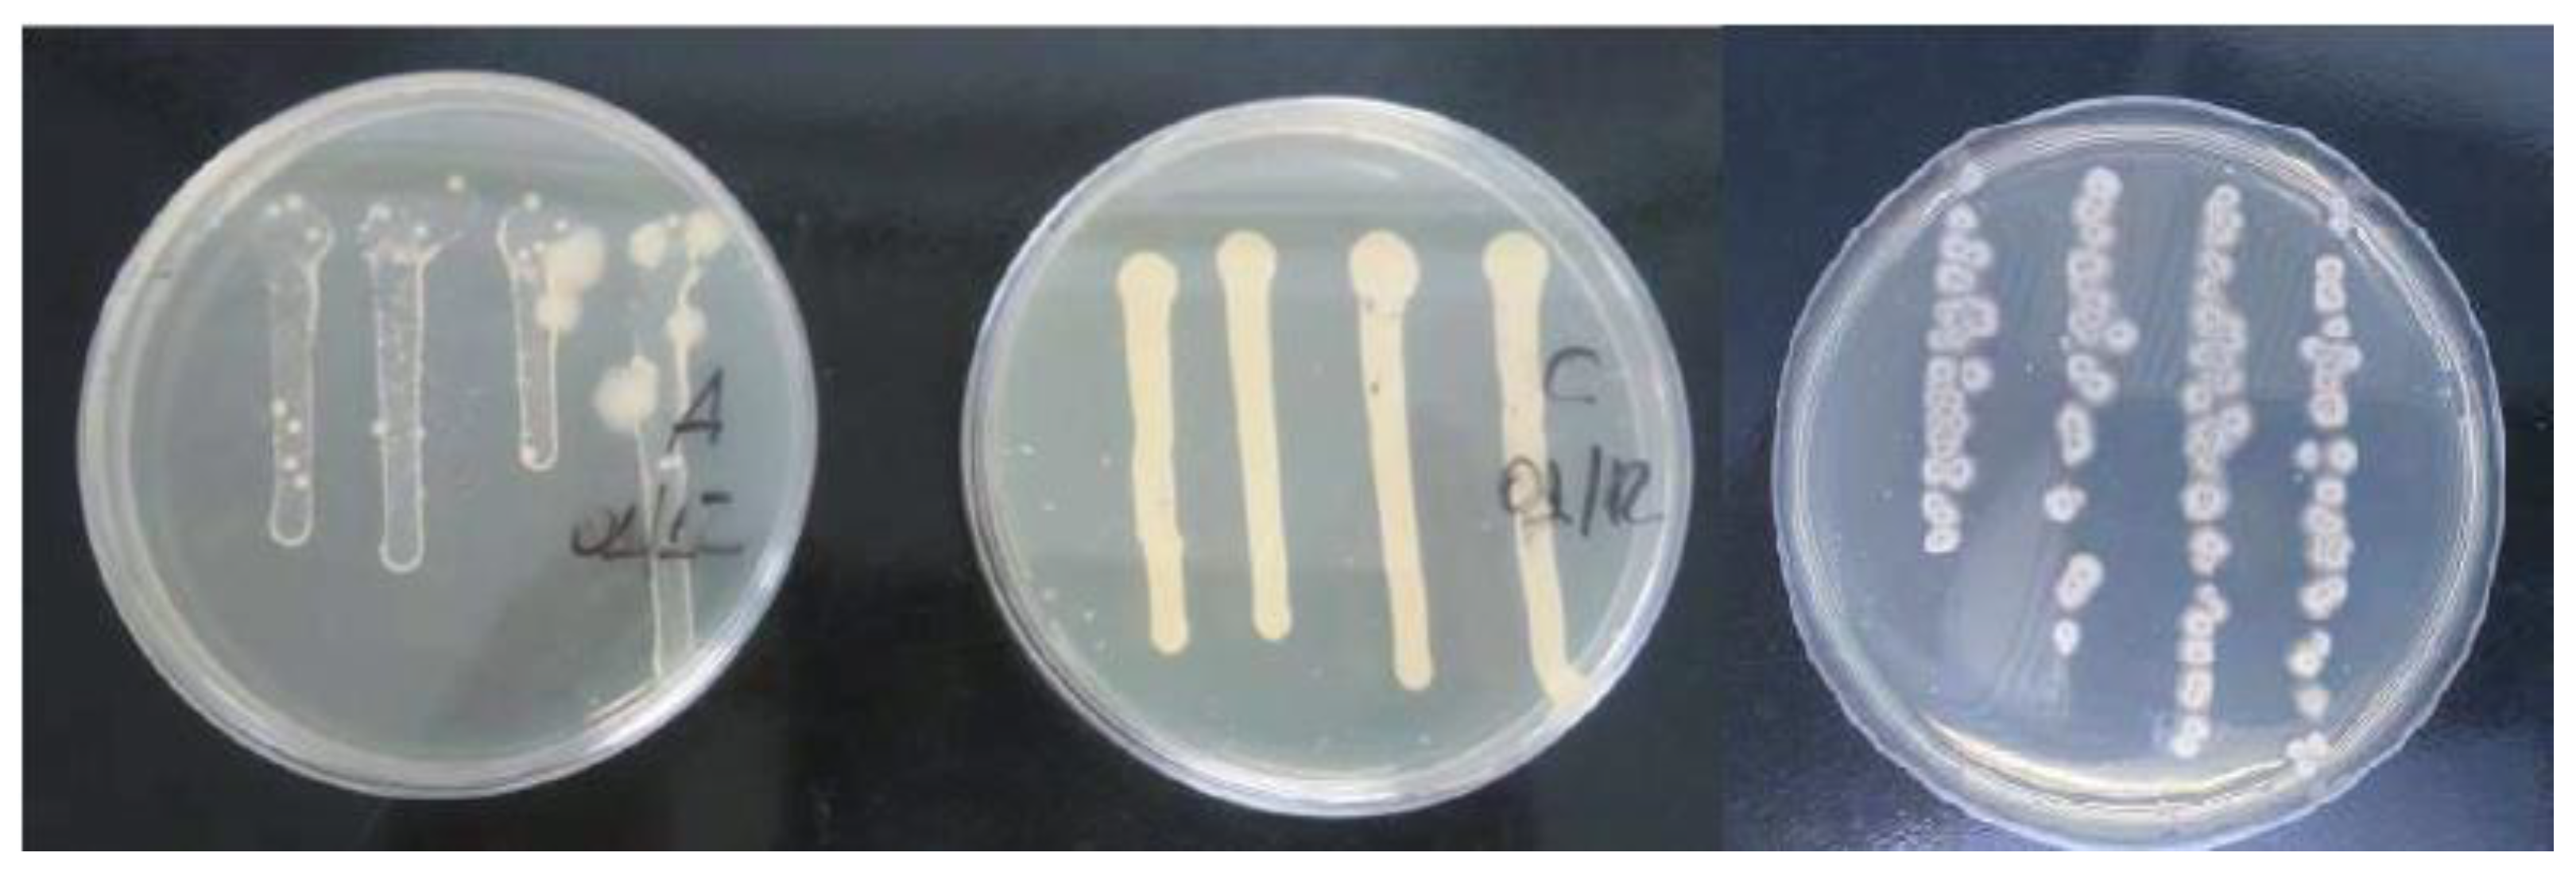
Lubricants 10 00309 g003

Flooding Application of Vegetable- and Mineral-Based Cutting Fluids in Turning of AISI 1050 Steel
Abstract
1. Introduction
2. Experimental Procedures
2.1. Workpiece Materials and Cutting Fluids
2.2. Methodology
2.3. Aging Tests for Microbiological Contamination
2.4. Tool Life Tests
2.5. Temperature Analysis
3. Results and Discussions
3.1. Microbiological Analysis
3.2. Tool Life
3.3. Tool Wear Analyses
3.4. Cutting Temperature Analysis
3.5. Surface Roughness Analysis
4. Conclusions
- For the microbiological aging test, despite all the fluids having similar performance, CF-C had slightly better results, resisting more microbiological contaminations than CF-A and CF-B, because of the more efficient inter-fungi and bacterial additives in the formulation of these fluids.
- Regarding tool life, CF-A had the best result, followed by CF-B and CF-C, with the dry cutting presenting the worst performance overall.
- In general, the type and wear mechanisms observed were flank and crater wear, and the prevailing wear mechanisms were attrition and micro abrasion with the lowest cutting speed (200 m/min), and attrition, micro abrasion, and diffusion wear mechanisms under the highest cutting speed (350 m/min).
- Regarding the average chip–tool interface temperatures, there are no significant differences for the lower cutting speeds, but for the highest cutting speed vc = 250 m/min, CF-C presented the best results (780 °C), followed by CF-B (820 °C), CF-A (880 °C), and dry condition (960 °C).
- Concerning the surface roughness values after the first pass in the tool life tests, the CF-C presented the best results, followed by the dry machining, CF-A, and CF-B.
- CF-A resulted in the longest tool life, good surface roughness, and good contamination stability, presenting the best overall performance.
Author Contributions
Funding
Data Availability Statement
Conflicts of Interest
References
- Siju, A.S.; Gajrani, K.K.; Joshi, S.S. Dual textured carbide tools for dry machining of titanium Alloys. Int. J. Refract. Met. Hard Mater. 2021, 94, 105403. [Google Scholar] [CrossRef]
- Dhage, S.; Jayal, A.D.; Sarkar, P. Effects of surface texture parameters of cutting tools on friction conditions at tool-chip interface during dry machining of AISI 1045 steel. Procedia Manuf. 2019, 33, 794–801. [Google Scholar] [CrossRef]
- Kumar, C.S.; Majumder, H.; Khan, A.; Patel, S.K. Applicability of DLC and WC/C low friction coatings on Al2O3/TiCN mixed ceramic cutting tools for dry machining of hardened 52100 steel. Ceram. Int. 2020, 46, 11889–11897. [Google Scholar] [CrossRef]
- Fernandes, G.H.N.; Lopes, G.H.F.; Barbosa, L.M.Q.; Martins, P.S.; Machado, Á.R. Wear mechanisms of diamond-like carbon coated tools in tapping of AA6351 T6 aluminium alloy. Procedia Manuf. 2021, 53, 293–298. [Google Scholar] [CrossRef]
- Debnath, S.; Reddy, M.M.; Pramanik, A. Dry and near-dry machining techniques for green manufacturing. In Innovations in Manufacturing for Sustainability; Springer: Berlin/Heidelberg, Germany, 2019; pp. 1–27. [Google Scholar]
- Brown, W.L.; Butler, R.G. Metalworking fluids. In Synthetics, Mineral Oils, and Bio-Based Lubricants; CRC Press: Boca Raton, FL, USA, 2020; pp. 751–778. [Google Scholar]
- Ravi, S.; Gurusamy, P.; Mohanavel, V. A review and assessment of effect of cutting fluids. Mater. Today Proc. 2021, 37, 220–222. [Google Scholar] [CrossRef]
- Abbas, A.T.; Benyahia, F.; El Rayes, M.M.; Pruncu, C.; Taha, M.A.; Hegab, H. Towards optimization of machining performance and sustainability aspects when turning AISI 1045 Steel under different cooling and lubrication strategies. Materials 2019, 12, 3023. [Google Scholar] [CrossRef] [PubMed]
- Revuru, R.S.; Zhang, J.Z.; Posinasetti, N.R.; Kidd, T. Optimization of titanium alloys turning operation in varied cutting fluid conditions with multiple machining performance characteristics. Int. J. Adv. Manuf. Technol. 2018, 95, 1451–1463. [Google Scholar] [CrossRef]
- Trent, E.M.; Wright, P.K. Metal Cutting; Butterworth-Heinemann: Boston, MA, USA, 2000. [Google Scholar]
- Rodriguez, R.L.; Lopes, J.C.; Mancini, S.D.; de Ângelo Sanchez, L.E.; de Almeida Varasquim, F.M.F.; Volpato, R.S.; de Mello, H.J.; de Aguiar, P.R.; Bianchi, E.C. Contribution for minimization the usage of cutting fluids in CFRP grinding. Int. J. Adv. Manuf. Technol. 2019, 103, 487–497. [Google Scholar] [CrossRef]
- Gajrani, K.K.; Suvin, P.S.; Kailas, S.V.; Sankar, M.R. Hard machining performance of indigenously developed green cutting fluid using flood cooling and minimum quantity cutting fluid. J. Clean. Prod. 2019, 206, 108–123. [Google Scholar] [CrossRef]
- Kipling, M.D. Health Hazards from Cutting Fluids. Tribol. Int. 1977, 10, 41–46. [Google Scholar] [CrossRef]
- Irani, R.A.; Bauer, R.J.; Warkentin, A. A review of cutting fluid application in the grinding process. Int. J. Mach. Tools Manuf. 2005, 45, 1696–1705. [Google Scholar] [CrossRef]
- Ezugwu, E.O.; Da Silva, R.B.; Bonney, J.; Machado, Á.R. The effect of argon-enriched environment in high-speed machining of titanium alloy. Tribol. Trans. 2005, 48, 18–23. [Google Scholar] [CrossRef]
- Sales, W.F.; Guimarães, G.; Machado, Á.R.; Ezugwu, E.O. Cooling ability of cutting fluids and measurement of the chip-tool interface temperatures. Ind. Lubr. Tribol. 2002, 54, 57–68. [Google Scholar] [CrossRef]
- King, N.; Keranen, L.; Gunter, K.; Sutherland, J. Wet versus Dry Turning: A Comparison of Machining Costs, Product Quality, and Aerosol Formation; SAE Technical Paper; SAE International: Warrendale, PA, USA, 2001. [Google Scholar]
- Sanchez, J.A.; Pombo, I.; Alberdi, R.; Izquierdo, B.; Ortega, N.; Plaza, S.; Martinez-Toledano, J. Machining evaluation of a hybrid MQL-CO2 grinding technology. J. Clean. Prod. 2010, 18, 1840–1849. [Google Scholar] [CrossRef]
- Srikant, R.R.; Rao, P.N. Use of vegetable-based cutting fluids for sustainable machining in sustainable machining. In Sustainable Machining; Springer: Cham, Switzerland, 2017; pp. 31–46. [Google Scholar]
- Ozimina, D.; Kowalczyk, J.; Madej, M.; Nowakowski, Ł.; Kulczycki, A. The impact of the type of cutting fluid on the turning process. Tribologia 2018, 273, 119–126. [Google Scholar] [CrossRef]
- Shashidhara, Y.M.Ã.; Jayaram, S.R. Tribology international vegetable oils as a potential cutting fluid—An evolution. Tribol. Int. 2010, 43, 1073–1081. [Google Scholar] [CrossRef]
- Debnath, S.; Reddy, M.M.; Yi, Q.S. Environmental friendly cutting fluids and cooling techniques in machining: A review. J. Clean. Prod. 2014, 83, 33–47. [Google Scholar] [CrossRef]
- Siniawski, M.T.; Saniei, N.; Adhikari, B.; Doezema, L.A. Influence of fatty acid composition on the tribological performance of two vegetable-based lubricants. J. Synth. Lubr. 2007, 24, 101–110. [Google Scholar] [CrossRef]
- Paul, S.; Pal, P.K. Study of surface quality during high speed machining using eco-friendly cutting fluid. Mach. Technol. Mater. 2011, 11, 24–28. [Google Scholar]
- Araújo Junior, A.S.; Sales, W.F.; da Silva, R.B.; Costa, E.S.; Rocha Machado, Á. Lubri-cooling and tribological behavior of vegetable oils during milling of aisi 1045 steel focusing on sustainable manufacturing. J. Clean. Prod. 2017, 156, 635–647. [Google Scholar] [CrossRef]
- Osama, M.; Singh, A.; Walvekar, R.; Khalid, M.; Gupta, T.C.S.M.; Yin, W.W. Recent developments and performance review of metal working fluids. Tribol. Int. 2017, 114, 389–401. [Google Scholar] [CrossRef]
- Lawal, S.A.; Choudhury, I.A.; Nukman, Y. Developments in the formulation and application of vegetable oil-based metalworking fluids in turning process. Int. J. Adv. Manuf. Technol. 2013, 67, 1765–1776. [Google Scholar] [CrossRef]
- Xavior, M.A.; Adithan, M. Determining the influence of cutting fluids on tool wear and surface roughness during turning of AISI 304 austenitic stainless steel. J. Mater. Process. Technol. 2009, 209, 900–909. [Google Scholar] [CrossRef]
- Katna, R.; Suhaib, M.; Agrawal, N. Nonedible vegetable oil-based cutting fluids for machining processes—A review. Mater. Manuf. Process. 2020, 35, 1–32. [Google Scholar] [CrossRef]
- Souza, M.C.; Gonçalves, J.F.S.; Gonçalves, P.C.; Lutif, S.Y.S.; Gomes, J.O. Use of jatropha and moringa oils for lubricants: Metalworking fluids more environmental-friendly. Ind. Crops Prod. 2019, 129, 594–603. [Google Scholar] [CrossRef]
- Carvalho, D.O.A.; da Silva, L.R.R.; Sopchenski, L.; Jackson, M.J.; Machado, Á.R. Performance evaluation of vegetable-based cutting fluids in turning of AISI 1050 steel. Int. J. Adv. Manuf. Technol. 2019, 103, 1603–1619. [Google Scholar] [CrossRef]
- ASTM E2275-14; Standard Practice for Evaluating Water-Miscible Metalworking Fluid Bioresistance and Antimicrobial Pesticide Performance. ASTM International: West Conshohocken, PA, USA, 2014.
- ISO 3685; Tool-Life Testing with a Single-Point Turning Tools. International Organization for Standardization: Geneve, Switzerland, 1993.
- Santos, M.C.; Araújo Filho, J.S.; Barrozo, M.A.S.; Jackson, M.J.; Machado, A.R. Development and application of a temperature measurement device using the tool-workpiece thermocouple method in turning at high cutting speeds. Int. J. Adv. Manuf. Technol. 2017, 89, 2287–2298. [Google Scholar] [CrossRef]
- Marques, A. Torneamento de Inconel 718 Com Aplicação de Lubrificantes Sólidos. Ph.D. Thesis, Universidade Federal de Uberlândia, Uberlândia, Brazil, 2015. (In Portuguese). [Google Scholar]
- Grossi, M.; Parolin, C.; Vitali, B.; Riccò, B. A Portable sensor system for bacterial concentration monitoring in metalworking fluids. J. Sens. Sens. Syst. 2018, 7, 349–357. [Google Scholar] [CrossRef]
- Finzi, M. Microbioma do Fluido de Corte Utilizado na Indústria Metal-Mecânica Brasileira: Composições Quantitativa e Qualitativa, Fatores que Influenciam a Presença de Microrganismos, Biodegradação e Impacto nas Propriedades Lubri-Refrigerante. Ph.D. Thesis, Universidade Federal de Uberlândia, Uberlândia, Brazil, 2015. (In Portuguese). [Google Scholar]
- Ozcelik, B.; Kuram, E.; Huseyin Cetin, M.; Demirbas, E. Experimental investigations of vegetable based cutting fluids with extreme pressure during turning of AISI 304l. Tribol. Int. 2011, 44, 1864–1871. [Google Scholar] [CrossRef]
- Jozić, S.; Vrsalović, L.; Bajić, D.; Gudić, S. Investigation of different cutting conditions in the machining of steel—Towards cleaner production. J. Clean. Prod. 2022, 356, 131881. [Google Scholar] [CrossRef]
- Ogedengbe, T.S.; Awe, P.; Joseph, O.I. Comparative analysis of machining stainless steel using soluble and vegetable oils as cutting fluids. Int. J. Eng. Mater. Manuf. 2019, 4, 33–40. [Google Scholar] [CrossRef]

| C | Mn | Si | P | Cu | S | Cr | Ni | Mo | Sn |
|---|---|---|---|---|---|---|---|---|---|
| 0.52 | 0.730 | 0.24 | 0.013 | 0.08 | 0.022 | 0.15 | 0.11 | 0.03 | 0.008 |
| Al | V | Nb | Ti | B | Ca | As | O | N | Fe |
| 0.016 | 0.02 | 0.001 | 0.0009 | 0.0004 | 0.0006 | 0.003 | 12 ppm | 83 ppm | Balance |
| Specific Weight ρ ton/m3 | Young Modulus E (GPa) | Shear Modulus G (GPa) | Ultimate Strength | Elongation Percent ε (%) | Coefficient. of Thermal Expansion α (10−6 C−1) | Vickers Hardness HV (400 N) | |
|---|---|---|---|---|---|---|---|
| Tensile σ (MPa) | Shear τ (MPa) | ||||||
| 7.86 | 210 | 80 | 340 | 200 | 15 | 11.7 | 255 |
| Cutting Fluid | Compound’s Name | % |
|---|---|---|
| A | Esters of phosphoric acid and neutralized amine | ≥6~<10 |
| Triethanolamine | ≥5~<10 | |
| Fatty acids, tall oils, ethoxylates | ≥5~<10 | |
| N,N′-methylenebisismorpholine alcohols | ≥3~<5 | |
| 3-iodo-2-propynyl butylcarbamate | ≥0.3~<1 | |
| B | Basic oil–highly refined | 15~20 |
| N,N-methylene bismorpholine | 5~10 | |
| Triethanolamine | 5~10 | |
| Esters of phosphoric acid and neutralized amine | 1~5 | |
| Amino-neutralized amine carboxylic acids | 1~5 | |
| 2-aminoethanol | 1~5 | |
| 2-Methylpentane-2,4-diol | 0.1~1 | |
| C | Triethanolamine | 20~25 |
| N,N-methylene bismorpholine | 1~5 |
| Fluid | Fluid A–An Emulsion of Vegetable Base | Fluid B–Semisynthetic of Mineral Base | Fluid C–Synthetic Vegetable Base | |
|---|---|---|---|---|
| Properties | ||||
| General characteristics | Bio-stable with anticorrosion properties; anti-foaming; free from boron, nitrites, and phenols; contains corrosion inhibitors, fatty acids, synthetic lubricants, and bactericide. | A chemical blend contains highly refined mineral oils, water, emulsifiers, performance additives, and biocides. | Bio-stable with anticorrosion properties; anti-foaming, free from boron, chlorinated paraffin, nitrites, and phenols; anti-corrosive, synthetic lubricants, and bactericide. | |
| pH (5% solution) | 9.1 | 9.5 | 9.2 | |
| Boiling point | above 100 °C | |||
| Flashpoint | Water-based product (not inflammable) | |||
| Density at 20 °C (g/mL) | 1.071 | 1.020 | 1.060 | |
| Solubility | Water soluble | |||
| Conditions | vc (m/min) | f (mm/rev) |
|---|---|---|
| 1 | 200 | 0.20 |
| 2 | 200 | 0.32 |
| 3 | 350 | 0.20 |
| 4 | 350 | 0.32 |
Publisher’s Note: MDPI stays neutral with regard to jurisdictional claims in published maps and institutional affiliations. |
© 2022 by the authors. Licensee MDPI, Basel, Switzerland. This article is an open access article distributed under the terms and conditions of the Creative Commons Attribution (CC BY) license (https://creativecommons.org/licenses/by/4.0/).
Share and Cite
Almeida Carvalho, D.O.; da Silva, L.R.R.; de Souza, F.C.R.; França, P.H.P.; Machado, Á.R.; Costa, E.S.; Fernandes, G.H.N.; da Silva, R.B. Flooding Application of Vegetable- and Mineral-Based Cutting Fluids in Turning of AISI 1050 Steel. Lubricants 2022, 10, 309. https://doi.org/10.3390/lubricants10110309
Almeida Carvalho DO, da Silva LRR, de Souza FCR, França PHP, Machado ÁR, Costa ES, Fernandes GHN, da Silva RB. Flooding Application of Vegetable- and Mineral-Based Cutting Fluids in Turning of AISI 1050 Steel. Lubricants. 2022; 10(11):309. https://doi.org/10.3390/lubricants10110309
Chicago/Turabian StyleAlmeida Carvalho, Déborah Oliveira, Leonardo Rosa Ribeiro da Silva, Felipe Chagas Rodrigues de Souza, Pedro Henrique Pires França, Álisson Rocha Machado, Eder Silva Costa, Gustavo Henrique Nazareno Fernandes, and Rosemar Batista da Silva. 2022. "Flooding Application of Vegetable- and Mineral-Based Cutting Fluids in Turning of AISI 1050 Steel" Lubricants 10, no. 11: 309. https://doi.org/10.3390/lubricants10110309
APA StyleAlmeida Carvalho, D. O., da Silva, L. R. R., de Souza, F. C. R., França, P. H. P., Machado, Á. R., Costa, E. S., Fernandes, G. H. N., & da Silva, R. B. (2022). Flooding Application of Vegetable- and Mineral-Based Cutting Fluids in Turning of AISI 1050 Steel. Lubricants, 10(11), 309. https://doi.org/10.3390/lubricants10110309

